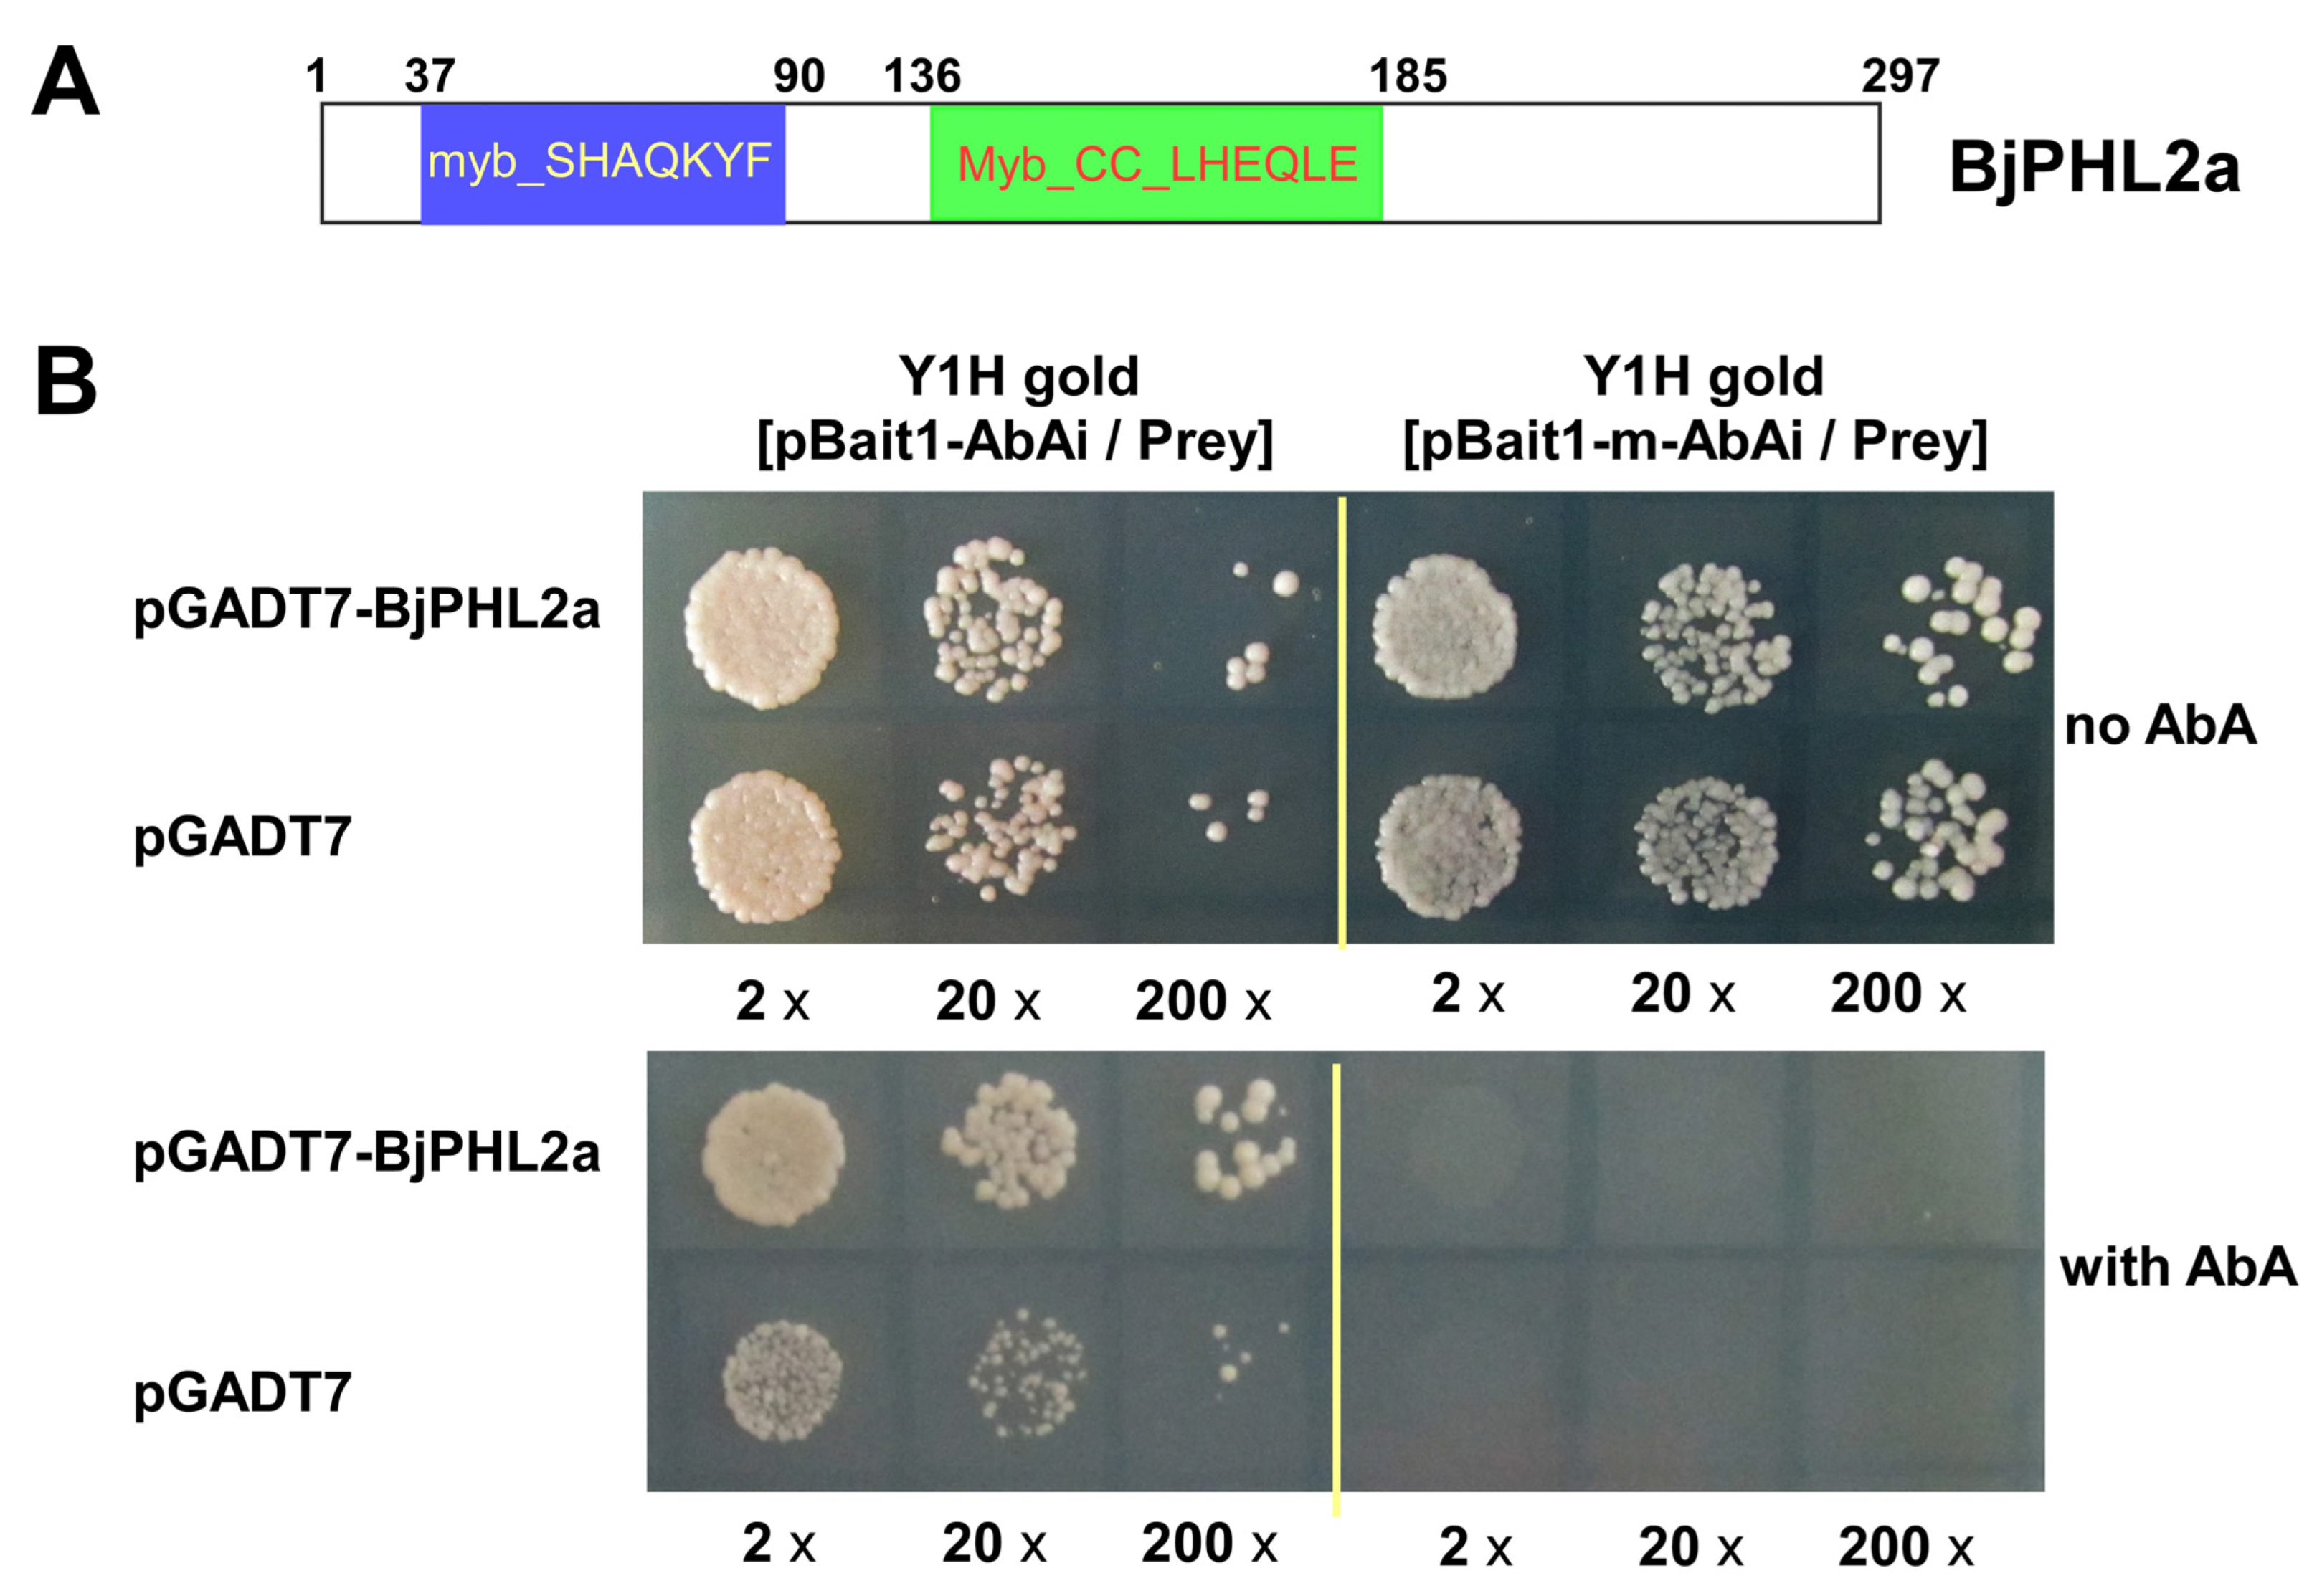

Genome-Wide Analysis of MYB Transcription Factor Gene Superfamily Reveals BjPHL2a Involved in Modulating the Expression of BjCHI1 in Brassica juncea
Abstract
1. Introduction
2. Results
2.1. Genome-Wide Identification of BjMYB Genes
2.2. Classification and Phylogenetic Analyses of BjMYB Proteins
2.3. Chromosomal Location of BjMYB Genes in Brassica juncea
2.4. Gene and Protein Structure Analyses of the BjMYB-CC Genes
2.5. Expression Profiles of BjMYB-CC Genes in Response to Abiotic Stresses
2.6. Expression of BjPHL2 Subclade Genes after Botrytis cinerea Infection
2.7. Isolation of BjPHL2a
2.8. BjPHL2a Encodes an MYB-CC Protein Located in the Nucleus
2.9. BjPHL2a Binds to the Wbl-4 Element In Vitro
2.10. BjPHL2a Activates a Mini-Promoter Containing a Wbl-4 Element In Vivo
3. Discussion
4. Materials and Methods
4.1. Identification of the MYB Gene Superfamily in Brassica juncea
4.2. Phylogenetic, Chromosome Distribution, Gene, and Protein Structure Analysis
4.3. Expression Profiles of the BjMYB-CC Genes
4.4. Plant Materials and Growth Conditions
4.5. Plasmid Construction
4.6. Yeast One-Hybrid Assay
4.7. Subcellular Localization of BjPHL2a
4.8. Protein Purification and Electrophoretic Mobility Shift Assay (EMSA)
4.9. Histochemical Staining of GUS and GUS Quantitative Assays
4.10. Determination of the Expression of BjPHL2a and its Paralogs after Botrytis cinerea Infection
5. Conclusions
Supplementary Materials
Author Contributions
Funding
Data Availability Statement
Acknowledgments
Conflicts of Interest
References
- Kang, L.; Qian, L.; Zheng, M.; Chen, L.; Chen, H.; Yang, L.; You, L.; Yang, B.; Yan, M.; Gu, Y.; et al. Genomic insights into the origin, domestication and diversification of Brassica juncea. Nat. Genet. 2021, 53, 1392–1402. [Google Scholar] [CrossRef]
- Yang, H.; Bayer, P.E.; Tirnaz, S.; Edwards, D.; Batley, J. Genome-wide identification and evolution of receptor-like kinases (RLKs) and receptor like proteins (RLPs) in Brassica juncea. Biology 2020, 10, 17. [Google Scholar] [CrossRef] [PubMed]
- Fisher, M.C.; Henk, D.A.; Briggs, C.J.; Brownstein, J.S.; Madoff, L.C.; McCraw, S.L.; Gurr, S.J. Emerging fungal threats to animal, plant and ecosystem health. Nature 2012, 484, 186–194. [Google Scholar] [CrossRef] [PubMed]
- Lenardon, M.D.; Munro, C.A.; Gow, N.A. Chitin synthesis and fungal pathogenesis. Curr. Opin. Microbiol. 2010, 13, 416–423. [Google Scholar] [CrossRef]
- Eckardt, N.A. Chitin signaling in plants: Insights into the perception of fungal pathogens and rhizobacterial symbionts. Plant Cell 2008, 20, 241–243. [Google Scholar] [CrossRef] [PubMed]
- Wan, J.; Zhang, X.C.; Stacey, G. Chitin signaling and plant disease resistance. Plant Signal. Behav. 2008, 3, 831–833. [Google Scholar] [CrossRef]
- Wang, P.; Hsu, C.C.; Du, Y.; Zhu, P.; Zhao, C.; Fu, X.; Zhang, C.; Paez, J.S.; Macho, A.P.; Tao, W.A.; et al. Mapping proteome-wide targets of protein kinases in plant stress responses. Proc. Natl. Acad. Sci. USA 2020, 117, 3270–3280. [Google Scholar] [CrossRef] [PubMed]
- Fung, K.L.; Zhao, K.J.; He, Z.M.; Chye, M.L. Tobacco-expressed Brassica juncea chitinase BjCHI1 shows antifungal activity in vitro. Plant Mol. Biol. 2002, 50, 283–294. [Google Scholar] [CrossRef]
- Wu, X.F.; Wang, C.L.; Xie, E.B.; Gao, Y.; Fan, Y.L.; Liu, P.Q.; Zhao, K.J. Molecular cloning and characterization of the promoter for the multiple stress-inducible gene BjCHI1 from Brassica juncea. Planta 2009, 229, 1231–1242. [Google Scholar] [CrossRef]
- Zhao, K.J.; Chye, M.L. Methyl jasmonate induces expression of a novel Brassica juncea chitinase with two chitin-binding domains. Plant Mol. Biol. 1999, 40, 1009–1018. [Google Scholar] [CrossRef]
- Gao, Y.; Zhao, K. Molecular mechanism of BjCHI1-mediated plant defense against Botrytis cinerea infection. Plant Signal. Behav. 2017, 12, e1271859. [Google Scholar] [CrossRef] [PubMed]
- Chye, M.L.; Zhao, K.J.; He, Z.M.; Ramalingam, S.; Fung, K.L. An agglutinating chitinase with two chitin-binding domains confers fungal protection in transgenic potato. Planta 2005, 220, 717–730. [Google Scholar] [CrossRef] [PubMed]
- Guan, Y.; Ramalingam, S.; Nagegowda, D.; Taylor, P.W.; Chye, M.L. Brassica juncea chitinase BjCHI1 inhibits growth of fungal phytopathogens and agglutinates Gram-negative bacteria. J. Exp. Bot. 2008, 59, 3475–3484. [Google Scholar] [CrossRef]
- Gao, Y.; Zan, X.L.; Wu, X.F.; Yao, L.; Chen, Y.L.; Jia, S.W.; Zhao, K.J. Identification of fungus-responsive cis-acting element in the promoter of Brassica juncea chitinase gene, BjCHI1. Plant Sci. 2014, 215, 190–198. [Google Scholar] [CrossRef] [PubMed]
- Gao, Y.; Jia, S.; Wang, C.; Wang, F.; Wang, F.; Zhao, K. BjMYB1, a transcription factor implicated in plant defence through activating BjCHI1 chitinase expression by binding to a W-box-like element. J. Exp. Bot. 2016, 67, 4647–4658. [Google Scholar] [CrossRef] [PubMed]
- Dubos, C.; Stracke, R.; Grotewold, E.; Weisshaar, B.; Martin, C.; Lepiniec, L. MYB transcription factors in Arabidopsis. Trends Plant Sci. 2010, 15, 573–581. [Google Scholar] [CrossRef]
- Bai, J.; Sun, F.; Wang, M.; Su, L.; Li, R. Genome-wide analysis of the MYB-CC gene family of maize. Genetica 2019, 147, 1–9. [Google Scholar] [CrossRef]
- Chiou, T.J.; Lin, S.I. Signaling network in sensing phosphate availability in plants. Annu. Rev. Plant Biol. 2011, 62, 185–206. [Google Scholar] [CrossRef]
- Motte, H.; Beeckman, T. PHR1 balances between nutrition and immunity in plants. Dev. Cell 2017, 41, 5–7. [Google Scholar] [CrossRef]
- Sega, P.; Pacak, A. Plant PHR transcription factors: Put on a map. Genes 2019, 10, 1018. [Google Scholar] [CrossRef]
- Wang, F.; Deng, M.; Xu, J.; Zhu, X.; Mao, C. Molecular mechanisms of phosphate transport and signaling in higher plants. Semin. Cell Dev. Biol. 2018, 74, 114–122. [Google Scholar] [CrossRef] [PubMed]
- Wang, Y.; Chen, Y.F.; Wu, W.H. Potassium and phosphorus transport and signaling in plants. J. Integr. Plant Biol. 2021, 63, 34–52. [Google Scholar] [CrossRef]
- Du, H.; Feng, B.R.; Yang, S.S.; Huang, Y.B.; Tang, Y.X. The R2R3-MYB transcription factor gene family in maize. PLoS ONE 2012, 7, e37463. [Google Scholar] [CrossRef] [PubMed]
- Katiyar, A.; Smita, S.; Lenka, S.K.; Rajwanshi, R.; Chinnusamy, V.; Bansal, K.C. Genome-wide classification and expression analysis of MYB transcription factor families in rice and Arabidopsis. BMC Genom. 2012, 13, 544. [Google Scholar] [CrossRef] [PubMed]
- Wang, Z.; Tang, J.; Hu, R.; Wu, P.; Hou, X.L.; Song, X.M.; Xiong, A.S. Genome-wide analysis of the R2R3-MYB transcription factor genes in Chinese cabbage (Brassica rapa ssp. pekinensis) reveals their stress and hormone responsive patterns. BMC Genom. 2015, 16, 17. [Google Scholar] [CrossRef]
- Gu, B.J.; Tong, Y.K.; Wang, Y.Y.; Zhang, M.L.; Ma, G.J.; Wu, X.Q.; Zhang, J.F.; Xu, F.; Li, J.; Ren, F. Genome-wide evolution and expression analysis of the MYB-CC gene family in Brassica spp. PeerJ 2022, 10, e12882. [Google Scholar] [CrossRef]
- Chen, D.; Chen, H.; Dai, G.; Zhang, H.; Liu, Y.; Shen, W.; Zhu, B.; Cui, C.; Tan, C. Genome-wide identification of R2R3-MYB gene family and association with anthocyanin biosynthesis in Brassica species. BMC Genom. 2022, 23, 441. [Google Scholar] [CrossRef]
- Hajiebrahimi, A.; Owji, H.; Hemmati, S. Genome-wide identification, functional prediction, and evolutionary analysis of the R2R3-MYB superfamily in Brassica napus. Genome 2017, 60, 797–814. [Google Scholar] [CrossRef]
- Abbas, F.; Ke, Y.; Zhou, Y.; Yu, Y.; Waseem, M.; Ashraf, U.; Wang, C.; Wang, X.; Li, X.; Yue, Y.; et al. Genome-wide analysis reveals the potential role of MYB transcription factors in floral scent formation in Hedychium coronarium. Front. Plant Sci. 2021, 12, 623742. [Google Scholar] [CrossRef]
- Ke, Y.J.; Zheng, Q.D.; Yao, Y.H.; Ou, Y.; Chen, J.Y.; Wang, M.J.; Lai, H.P.; Yan, L.; Liu, Z.J.; Ai, Y. Genome-wide identification of the MYB gene family in Cymbidium ensifolium and its expression analysis in different flower colors. Int. J. Mol. Sci. 2021, 22, 13245. [Google Scholar] [CrossRef]
- Abubakar, A.S.; Feng, X.; Gao, G.; Yu, C.; Chen, J.; Chen, K.; Wang, X.; Mou, P.; Shao, D.; Chen, P.; et al. Genome wide characterization of R2R3 MYB transcription factor from Apocynum venetum revealed potential stress tolerance and flavonoid biosynthesis genes. Genomics 2022, 114, 110275. [Google Scholar] [CrossRef] [PubMed]
- Duan, A.Q.; Tan, S.S.; Deng, Y.J.; Xu, Z.S.; Xiong, A.S. Genome-wide identification and evolution analysis of R2R3-MYB gene family reveals S6 subfamily R2R3-MYB transcription factors involved in anthocyanin biosynthesis in carrot. Int. J. Mol. Sci. 2022, 23, 11859. [Google Scholar] [CrossRef] [PubMed]
- Zhang, H.; Liu, Z.; Luo, R.; Sun, Y.; Yang, C.; Li, X.; Gao, A.; Pu, J. Genome-wide characterization, identification and expression profile of MYB transcription factor gene family during abiotic and biotic stresses in mango (Mangifera indica). Plants 2022, 11, 3141. [Google Scholar] [CrossRef] [PubMed]
- Liu, Y.; Zhang, Z.; Fang, K.; Shan, Q.; He, L.; Dai, X.; Zou, X.; Liu, F. Genome-wide analysis of the MYB-related transcription factor family in pepper and functional studies of CaMYB37 involvement in capsaicin biosynthesis. Int. J. Mol. Sci. 2022, 23, 11667. [Google Scholar] [CrossRef] [PubMed]
- Sabir, I.A.; Manzoor, M.A.; Shah, I.H.; Liu, X.; Zahid, M.S.; Jiu, S.; Wang, J.; Abdullah, M.; Zhang, C. MYB transcription factor family in sweet cherry (Prunus avium L.): Genome-wide investigation, evolution, structure, characterization and expression patterns. BMC Plant Biol. 2022, 22, 2. [Google Scholar] [CrossRef]
- Bai, Y.; Zhu, W.; Hu, X.; Sun, C.; Li, Y.; Wang, D.; Wang, Q.; Pei, G.; Zhang, Y.; Guo, A.; et al. Genome-wide analysis of the bZIP gene family identifies two ABI5-like bZIP transcription factors, BrABI5a and BrABI5b, as positive modulators of ABA signalling in Chinese cabbage. PLoS ONE 2016, 11, e0158966. [Google Scholar] [CrossRef]
- Bhardwaj, A.R.; Joshi, G.; Kukreja, B.; Malik, V.; Arora, P.; Pandey, R.; Shukla, R.N.; Bankar, K.G.; Katiyar-Agarwal, S.; Goel, S.; et al. Global insights into high temperature and drought stress regulated genes by RNA-Seq in economically important oilseed crop Brassica juncea. BMC Plant Biol. 2015, 15, 9. [Google Scholar] [CrossRef]
- Yang, J.; Liu, D.; Wang, X.; Ji, C.; Cheng, F.; Liu, B.; Hu, Z.; Chen, S.; Pental, D.; Ju, Y.; et al. The genome sequence of allopolyploid Brassica juncea and analysis of differential homoeolog gene expression influencing selection. Nat. Genet. 2016, 48, 1225–1232. [Google Scholar] [CrossRef]
- Sun, L.; Song, L.; Zhang, Y.; Zheng, Z.; Liu, D. Arabidopsis PHL2 and PHR1 act redundantly as the key components of the central regulatory system controlling transcriptional responses to phosphate starvation. Plant Physiol. 2016, 170, 499–514. [Google Scholar] [CrossRef]
- Ruan, W.; Guo, M.; Wu, P.; Yi, K. Phosphate starvation induced OsPHR4 mediates Pi-signaling and homeostasis in rice. Plant Mol. Biol. 2017, 93, 327–340. [Google Scholar] [CrossRef]
- Jiang, M.; Sun, L.; Isupov, M.N.; Littlechild, J.A.; Wu, X.; Wang, Q.; Wang, Q.; Yang, W.; Wu, Y. Structural basis for the target DNA recognition and binding by the MYB domain of phosphate starvation response 1. FEBS J. 2019, 286, 2809–2821. [Google Scholar] [CrossRef]
- Bustos, R.; Castrillo, G.; Linhares, F.; Puga, M.I.; Rubio, V.; Perez-Perez, J.; Solano, R.; Leyva, A.; Paz-Ares, J. A central regulatory system largely controls transcriptional activation and repression responses to phosphate starvation in Arabidopsis. PLoS Genet. 2010, 6, e1001102. [Google Scholar] [CrossRef]
- Castrillo, G.; Teixeira, P.J.; Paredes, S.H.; Law, T.F.; de Lorenzo, L.; Feltcher, M.E.; Finkel, O.M.; Breakfield, N.W.; Mieczkowski, P.; Jones, C.D.; et al. Root microbiota drive direct integration of phosphate stress and immunity. Nature 2017, 543, 513–518. [Google Scholar] [CrossRef]
- Shi, J.; Zhao, B.; Zheng, S.; Zhang, X.; Wang, X.; Dong, W.; Xie, Q.; Wang, G.; Xiao, Y.; Chen, F.; et al. A phosphate starvation response-centered network regulates mycorrhizal symbiosis. Cell 2021, 184, 5527–5540.e5518. [Google Scholar] [CrossRef]
- Barco, B.; Clay, N.K. Hierarchical and dynamic regulation of defense-responsive specialized metabolism by WRKY and MYB transcription factors. Front. Plant Sci. 2019, 10, 1775. [Google Scholar] [CrossRef]
- Eulgem, T.; Somssich, I.E. Networks of WRKY transcription factors in defense signaling. Curr. Opin. Plant Biol. 2007, 10, 366–371. [Google Scholar] [CrossRef] [PubMed]
- Chen, H.; Wang, T.; He, X.; Cai, X.; Lin, R.; Liang, J.; Wu, J.; King, G.; Wang, X. BRAD V3.0: An upgraded Brassicaceae database. Nucleic Acids Res. 2022, 50, D1432–D1441. [Google Scholar] [CrossRef]
- Song, M.; Linghu, B.; Huang, S.; Li, F.; An, R.; Xie, C.; Zhu, Y.; Hu, S.; Mu, J.; Zhang, Y. Genome-wide survey of leucine-rich repeat receptor-like protein kinase genes and CRISPR/Cas9-targeted mutagenesis BnBRI1 in Brassica napus. Front. Plant Sci. 2022, 13, 865132. [Google Scholar] [CrossRef] [PubMed]
- Li, G.; Hu, X.; Hou, L.; Cao, L.; Wang, Q.; Wang, D.; Mu, X.; Zhang, Y.; Zhou, X.; Zhao, Y.; et al. Molecular identification of BrHAB2a, one of the two AtHAB2-like proteins in Brassica rapa, is an important component of ABA signaling. Biochem. Biophys. Res. Commun. 2018, 503, 495–500. [Google Scholar] [CrossRef] [PubMed]
- Zhou, X.; Hao, H.; Zhang, Y.; Bai, Y.; Zhu, W.; Qin, Y.; Yuan, F.; Zhao, F.; Wang, M.; Hu, J.; et al. SOS2-LIKE PROTEIN KINASE5, an SNF1-RELATED PROTEIN KINASE3-type protein kinase, is important for abscisic acid responses in Arabidopsis through phosphorylation of ABSCISIC ACID-INSENSITIVE5. Plant Physiol. 2015, 168, 659–676. [Google Scholar] [CrossRef] [PubMed]
- Zhou, X.; Yuan, F.; Wang, M.; Guo, A.; Zhang, Y.; Xie, C.G. Molecular characterization of an ABA insensitive 5 orthologue in Brassica oleracea. Biochem. Biophys. Res. Commun. 2013, 430, 1140–1146. [Google Scholar] [CrossRef] [PubMed]

Disclaimer/Publisher’s Note: The statements, opinions and data contained in all publications are solely those of the individual author(s) and contributor(s) and not of MDPI and/or the editor(s). MDPI and/or the editor(s) disclaim responsibility for any injury to people or property resulting from any ideas, methods, instructions or products referred to in the content. |
© 2023 by the authors. Licensee MDPI, Basel, Switzerland. This article is an open access article distributed under the terms and conditions of the Creative Commons Attribution (CC BY) license (https://creativecommons.org/licenses/by/4.0/).
Share and Cite
Xie, C.G.; Jin, P.; Xu, J.; Li, S.; Shi, T.; Wang, R.; Jia, S.; Zhang, Z.; Guo, W.; Hao, W.; et al. Genome-Wide Analysis of MYB Transcription Factor Gene Superfamily Reveals BjPHL2a Involved in Modulating the Expression of BjCHI1 in Brassica juncea. Plants 2023, 12, 1011. https://doi.org/10.3390/plants12051011
Xie CG, Jin P, Xu J, Li S, Shi T, Wang R, Jia S, Zhang Z, Guo W, Hao W, et al. Genome-Wide Analysis of MYB Transcription Factor Gene Superfamily Reveals BjPHL2a Involved in Modulating the Expression of BjCHI1 in Brassica juncea. Plants. 2023; 12(5):1011. https://doi.org/10.3390/plants12051011
Chicago/Turabian StyleXie, Chang Gen, Ping Jin, Jiamin Xu, Shangze Li, Tiantian Shi, Rui Wang, Shuangwei Jia, Zixuan Zhang, Weike Guo, Wenfang Hao, and et al. 2023. "Genome-Wide Analysis of MYB Transcription Factor Gene Superfamily Reveals BjPHL2a Involved in Modulating the Expression of BjCHI1 in Brassica juncea" Plants 12, no. 5: 1011. https://doi.org/10.3390/plants12051011
APA StyleXie, C. G., Jin, P., Xu, J., Li, S., Shi, T., Wang, R., Jia, S., Zhang, Z., Guo, W., Hao, W., Zhou, X., Liu, J., & Gao, Y. (2023). Genome-Wide Analysis of MYB Transcription Factor Gene Superfamily Reveals BjPHL2a Involved in Modulating the Expression of BjCHI1 in Brassica juncea. Plants, 12(5), 1011. https://doi.org/10.3390/plants12051011

